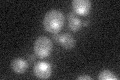
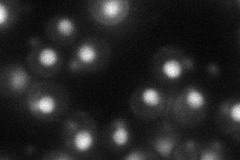
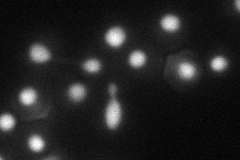
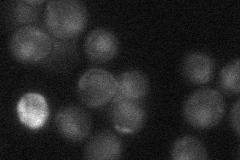
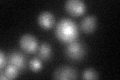
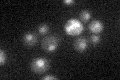

View description
JmjC domain family histone demethylase specific for H3-K4 (histone H3 Lys4); removes methyl groups specifically added by Set1p methyltransferase; protein levels regulated by Not4p (E3 ubiquitin ligase) polyubiquitin-mediated degradation
Localization:
Intensity:
Fold change:
Significance:
-
C’ GFP library in SD
nucleus19.58 -
N' NOP1pr-GFP in SD
nucleus47.1889 -
N' TEF2pr-mCherry in SD
nucleus28.6498 -
N' NATIVEpr-GFP in SD
nucleus21.8463 -
N' TEF2pr-VC and Cyto-VN in SD

nucleus26.5897 -
C’ GFP library in SD+DTT
nucleus22.261.13No -
C’ GFP library in SD+H2O2

nucleus20.241.03No -
C’ GFP library in Starvation Media
nucleus21.021.07No -
C’ GFP library on the background of Pup2-DaMP

nucleus -
C’ GFP library on the background of CCT mutant

nucleus18.38020.938235No
